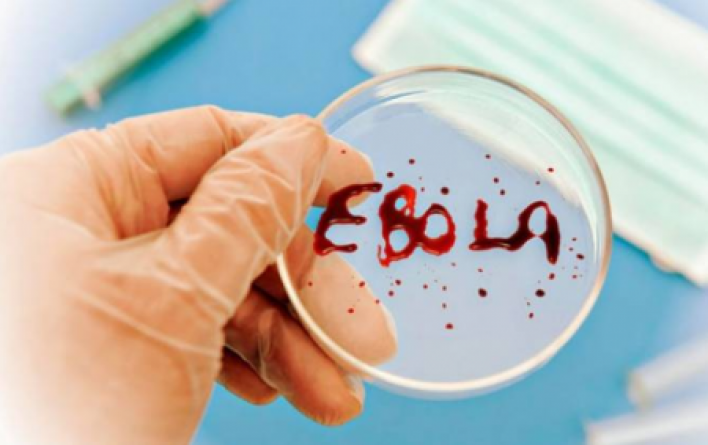

ԿԴՀ-ում հայտնաբերվել է Էբոլա վիրուսի վտանգավոր «զաիրյան մանրԷահիմք»

Կոնգոյի Դեմոկրատական Հանրապետության (ԿԴՀ) Հյուսիսային Կիվուի նահանգում գրանցվել Է Էբոլա վիրուսի չափազանց վտանգավոր «զաիրյան մանրԷահիմքը»,որն աչքի Է ընկնում բարձր մահացությամբ: Այս մասին, հայտնել Է Առողջապահության համաշխարհային կազմակերպությունը (ԱՀԿ)՝ երկրում կատարված գենետիկական հետազոտությունների արդյունքներով:
«Գենետիկական անալիզը հաստատեց «զաիրյան մանրԷահիմքի» առկայությունը»,- Twitter-ում գրել Է ԱՀԿ-ի գլխավոր տնօրենի տեղակալ Փիտեր Սալաման,որը ղեկավարում Է արտակարգ իրավիճակների արձագանքումը: